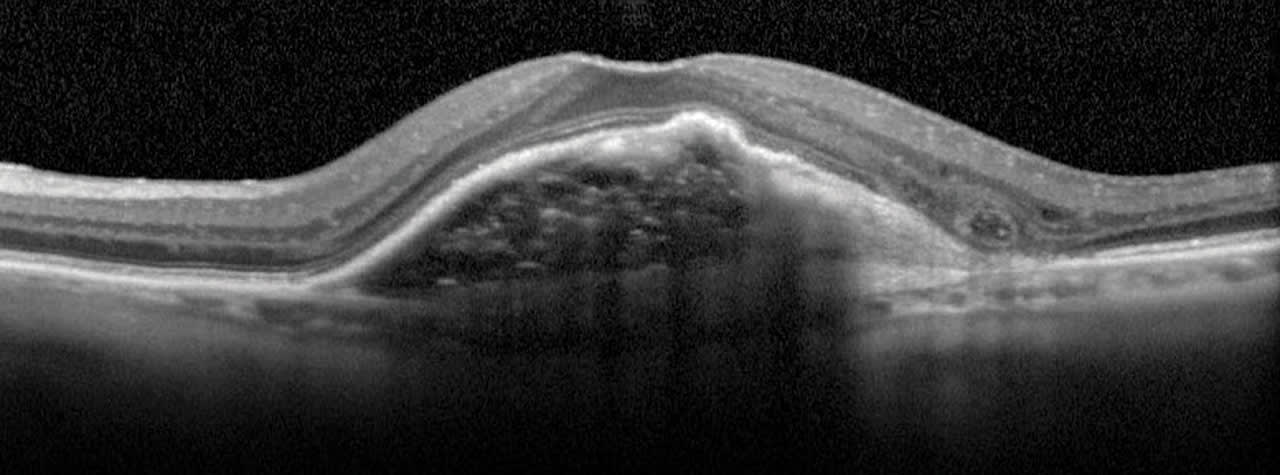
Figure 1. RPE detachment imaged with conventional scan
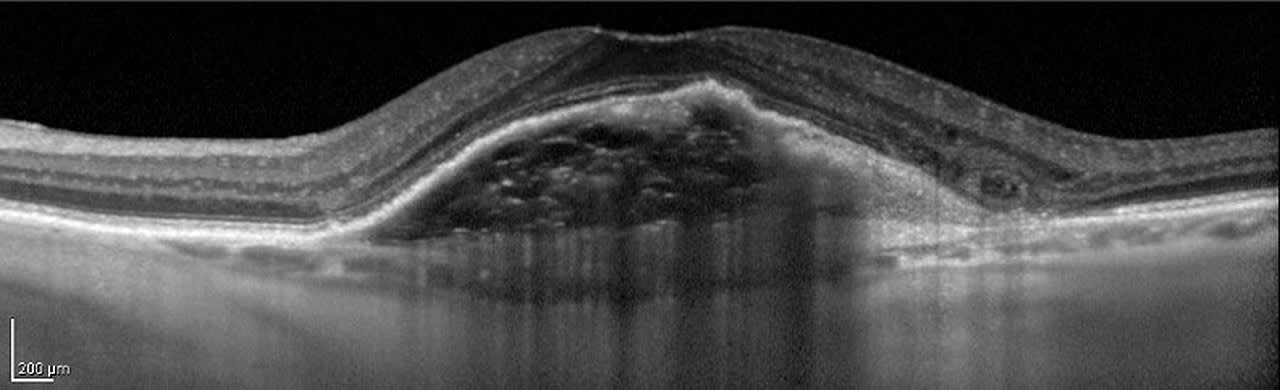
Figure 2. Same pathology imaged with EDI scan (note loss of data resolution at anterior edge of retina)
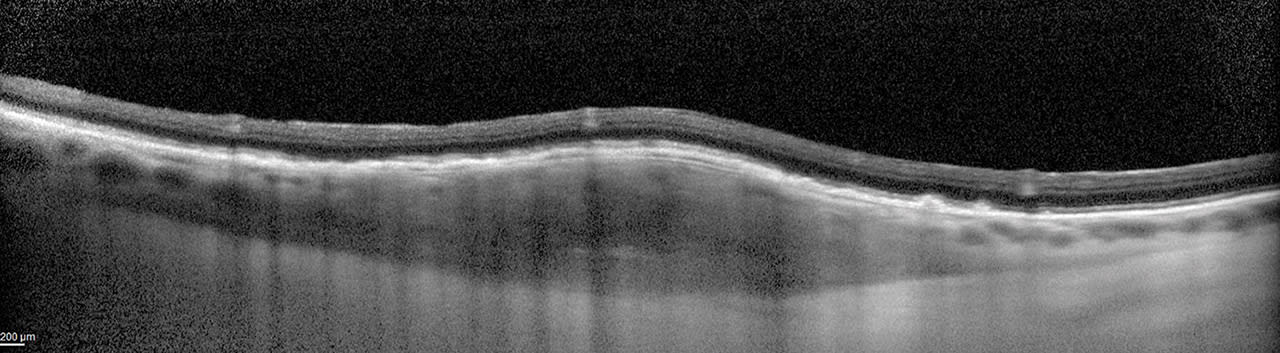
Figure 3. EDI allows for accurate visualization of a mass from anterior to posterior demarcation.
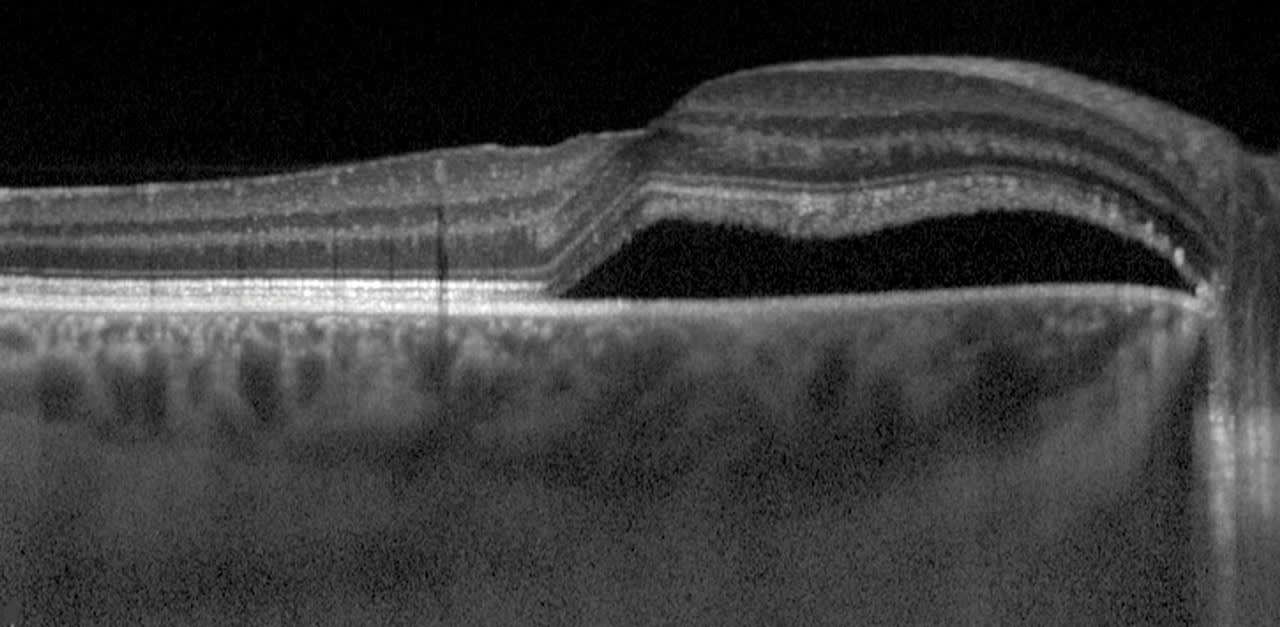
Figure 4 (top) and 5 (bottom). Thickened choroid under the area of subretinal fluid is evident in these EDI OCT scans, confirming the diagnosis of CSCR.
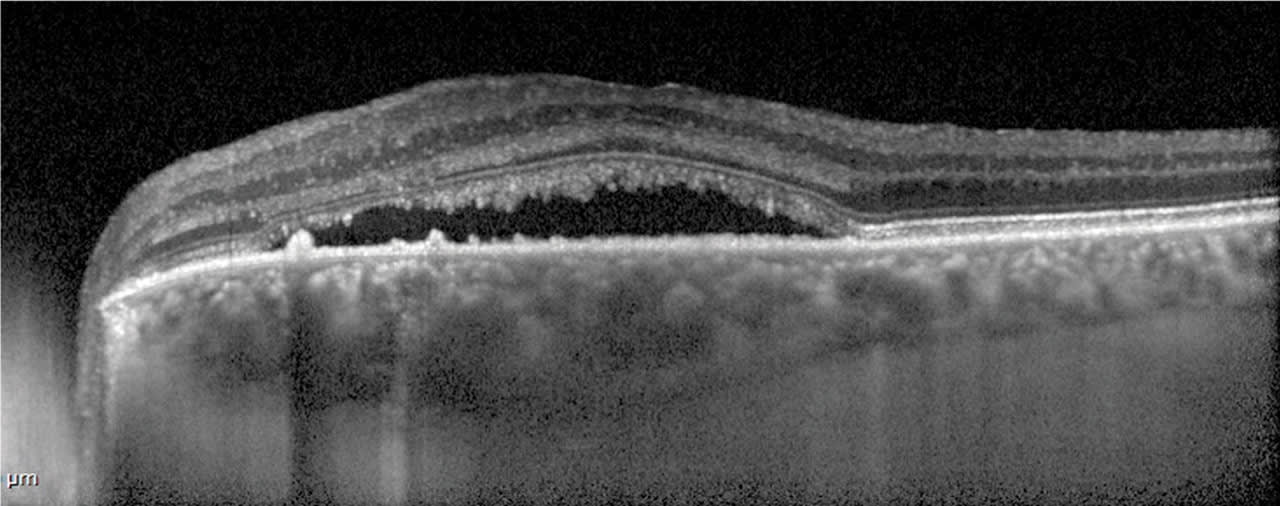

Most articles on optical coherence tomography (OCT) imaging that are intended for non-physicians emphasize the basics of OCT and common scan techniques. However, in short time, imagers may be faced with uncommon pathology or other challenging situations.
In this article, we will discuss a few tips that may assist in acquiring the best scan and provide the most data in these cases.
1. Enhanced depth imaging
Enhanced depth imaging (EDI) is a scan option on most commercially available OCT systems. It allows for a “deeper” scan, capturing more of the deeper retina and choroidal structures. This technique is useful for any pathology that is in the deeper layers, such as choroidal neovascularization, tumors and choroidal thickness analysis. The scan depth of a typical spectral domain OCT allows for more data of structures from the vitreo-retinal interface to the retinal pigment epithelium. EDI scans adjust for further enhancement of the deeper layers, and provides data from (approximately) the inner plexiform layer to the sclera, resulting in more data resolution of those layers. (Figures 1 and 2)

EDI is a very useful tool in evaluating nevus vs tumor in the choroid, as the posterior edge of a mass is reflective, allowing for more accurate measurements (Figure 3).
Central serous chorioretinopathy (CSCR) can present on standard OCT with subretinal fluid and no elevation of the retinal pigment epithelium (Figures 4 and 5). In these eyes, the choroidal thickness can be increased under the area of subretinal fluid. This finding can assist in differentiation from other pathology, such as choroidal neovascularization.1

2. CT scans making the diagnosis
In some cases, a “simple” OCT scan can confirm or better illustrate a diagnosis. One of the more common uses of this is in the case of determining a retinal detachment vs retinoschisis. When done properly, OCT can provide definitive data to differentiate between an actual retinal detachment, a separation of all retinal layers or retinoschisis, which is a separation within the normal retinal layers (Figures 6 and 7)


Another common use of diagnostic OCT is to evaluate drusen, which are aging deposits of lipids and proteins under the retina.2 The different types of drusen are evident on OCT B-scans: soft drusen, hard drusen and reticular pseudodrusen.
Soft drusen develop under the RPE and have a round, dome appearance. (Figure 8a). Hard drusen are also sub-RPE but have a conical or peaked appearance (Figure 8b). Reticular pseudodrusen are present above the RPE (Figure 9) and can provide further prognostic value, as patients with RPD have a significant risk for the progression of age-related macular degeneration (AMD).3



Outer retinal tubulation (ORT) is another instance where OCT provides prognostic value. ORT are tubular structures typically found in the outer nuclear layer in advanced AMD4 and are the scrolling of the external limiting membrane and photoreceptor inner segments, the result of restructuring of degenerative photoreceptor cells. They are easily identified by the hyperreflective band and hypo-reflective cavity (Figure 10). In the presence of ORT, the prognosis for recoverable vision is very unlikely.5
Conclusion
This article highlights only a sampling of what OCT can provide, if the imager thinks about more than just acquiring quality scans. As imagers, we provide data that is immensely valuable to the clinician from a diagnostic, treatment and prognostic standpoint. As with any ophthalmic imaging, patterns emerge over time, and the imager that pays attention and recognizes these patterns is an invaluable asset to patient care. OP
REFERENCES:
1. Hanumunthadu D, van Dijk EHC, Dumpala S, et al. Evaluation of Choroidal Layer Thickness in Central Serous Chorioretinopathy. J Ophthalmic Vis Res. 2019:164-170.
2. American Academy of Ophthalmology. What Are Drusen? https://tinyurl.com/4nsczarx. Accessed July 10, 2024.
3. Spaide RF, Curcio CA. Drusen characterization with multimodal imaging. Retina. 2010; 30:1441-1454.
4. Schaal KB, Freund KB, Litts KM, Zhang Y, Messinger JD, Curcio CA. Outer Retinal Tubulation In Advanced Age-Related Macular Degeneration: Optical Coherence Tomographic Findings Correspond to Histology. Retina. 2015;35:1339-1350.
5. Roach L, Freund KB, Curcio CA, et al. Outer Retinal Tubulation: Sign of Neurodegeneration. Eyenet Magazine. Jan 2018;31-32.









